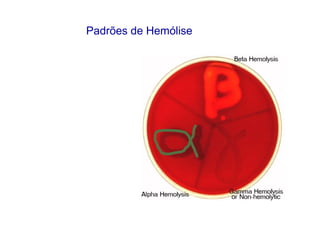
Padrões de Hemólise
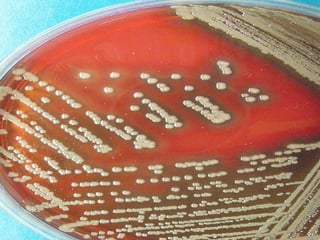
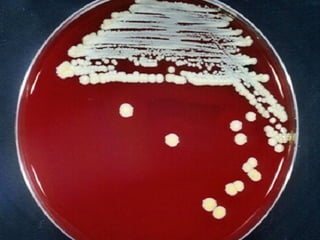
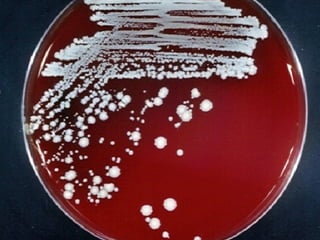
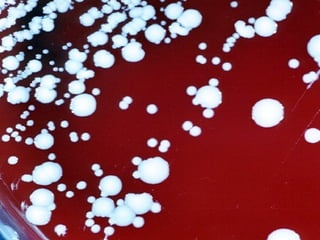
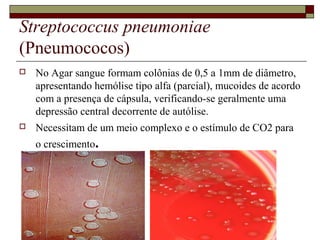
Streptococcus pneumoniae
(Pneumococos)
 No Agar sangue formam colônias de 0,5 a 1mm de diâmetro,
apresentando hemólise tipo alfa (parcial), mucoides de acordo
com a presença de cápsula, verificando-se geralmente uma
depressão central decorrente de autólise.
 Necessitam de um meio complexo e o estímulo de CO2 para
o crescimento.
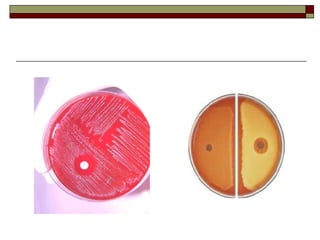
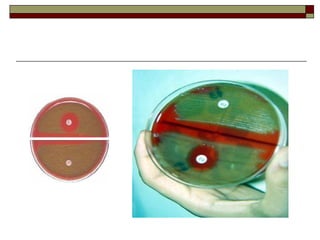

O documento descreve as características gerais de bactérias, incluindo sua biologia, nutrição, divisão e tipos principais. Ele também discute vários gêneros de bactérias gram-positivas e gram-negativas, mecanismos de patogenicidade, microbiota normal e transmissão de doenças.